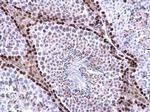
WAC Antibody in Immunohistochemistry (Paraffin) (IHC (P))

Search
Invitrogen
WAC Polyclonal Antibody
{{$productOrderCtrl.translations['antibody.pdp.commerceCard.promotion.promotions']}}
{{$productOrderCtrl.translations['antibody.pdp.commerceCard.promotion.viewpromo']}}
{{$productOrderCtrl.translations['antibody.pdp.commerceCard.promotion.promocode']}}: {{promo.promoCode}} {{promo.promoTitle}} {{promo.promoDescription}}. {{$productOrderCtrl.translations['antibody.pdp.commerceCard.promotion.learnmore']}}
图: 1 / 4
WAC Antibody (PA5-85683) in IHC (P)

产品信息
PA5-85683
宿主/亚型
分类
类型
抗原
偶联物
形式
浓度
规格
保存条件
运输条件
RRID
产品详细信息
Keep as concentrated solution.
Predicted reactivity: Mouse (94%), Rat (91%).
Store product as a concentrated solution. Centrifuge briefly prior to opening the vial.
靶标信息
The WW domain containing adaptor with coiled-coil protein (WAC) contains a WW domain that mediates protein-protein interactions and colocalizes with RNA splicing factor SC35. Further studies have indicated that WAC is a functional partner of the RNF20/40 complex that ubiquitinates Histone H2B, and that WAC regulates H2B ubiquitination. WAC targets RNF20/40 to associate with RNA polymerase II complex for H2B ubiquitination at active transcription sites. WAC-dependent transcription is also important for cell-cycle checkpoint activation in response to genotoxic stress.
仅用于科研。不用于诊断过程。未经明确授权不得转售。




